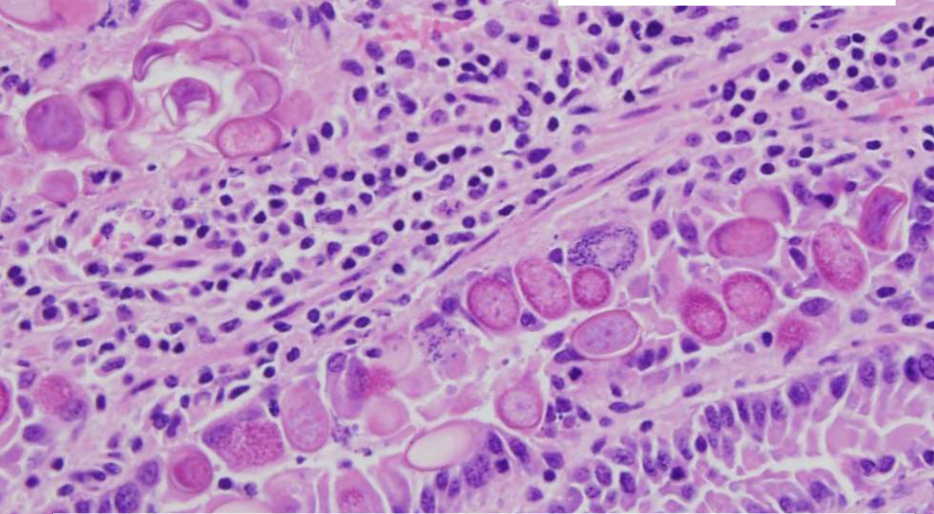

What is the GI water cycle?
- Secretions and intake ~9L/day
- SI is major absorptive site
- Significant absorption in colon (esp. horses)

What are the mechanisms for diarrhea?
- Malabsorption - osmotic diarrhea, usually SI
- Hypersecretion - structurally intact mucosa
- occurs as a result of net efflux of fluid and electrolytes independent of permeability changes or absorptive capacity
- Exudation - increased capillary pressure or epithelial permeability (PLE, Lymphangiectasia is a good ex)
- Hypermotility
What are the common causes of diarrhea in pigs from most to least?
- Atrophic enteritis
- idiopathic
- E.coli (ETEC)
- Rotavirus
- C. diff
- C. perf type A
- TGE
- Coccidia
- C. diff type C
What are the common causes of diarrhea in calves?
- Rotavirus
- Cryptosporidium
- Coronavirus
- Corona/crypto mix
- Rota/corona mix
- Rota/crypto mix
What are the Bovine viral agents for neonatal diarrhea?
- Bovine Viral Enteritis
- multiplication in villous intestinal epithelial cells
- Fecal - oral transmission
- Bovine Enteric CoV
- common
- often involves other agents (rota, crypto)
- Causes fibrinonecrotic colitis
- Bovine Rotavirus
- Ubiquitous- mostly group A/B/C rotavirus
- mostly subclinical - severity is a function of exposure dose, age, immunity
- Co-infections common (corona, crypto)
What is the Dx approach for viral ovine neonatal diarrhea?
- Fixed SI/colon for histology and IHC
- Fresh/frozen for viral detection (PCR, panels)
What are the viral agents responsible for swine neonatal diarrhea?
- Transmissible gastroenteritis Virus (TGE)
- Coronavirus historically common in suckling/nursery pigs
- mostly eradicated today by vaccination
- Cause of diarrhea, vomiting - any age
- Porcine epidemic diarrhea Virus (PED)
- TGE-like coronavirus
- Emerged in US Spring 2013
- NOT detected by TGE molecular tests
- Porcine delta coronavirus (PDCoV)
- Similar clinical signs, detected in wake of PED
- Probably less virulent
- Swine acute diarrhea syndrome (SADS)
- Swine rotavirus group A/B/C
- Rotavirus:
- ubiquitous
- mostly subclinical
- severity depends on dose, age, immunity
How doe viral agents cause diarrhea in swine neonates?
- Fecal-oral transmission
- multiply in villous intestinal epithelial cells
- villous atrophy
How are viral agents of porcine neonatal diarrhea Dx?
- Fixed SI for histology and ICH
- Fresh/frozen tissue for viral detection (usually PCR)
Morphologic Dx? Pathogenesis?

- SI; villous atrophy/blunting and fusion (crypts are intact)
- Viral infection of villar tip epithelium
- necrosis of epithelium at tips
- villous atrophy
- healing by adjacent epithelium and cy crypt hyperplasia
- villous fusion
Morphologic Dx? Pathogenesis?

- SI: villous atrophy, blunting, and fusion
1. Enteric coronavirus (TGEV) infection of tip villar epithelium
How does Cryptosporidium parvum cause diarrhea
- Protozoa colonize villi
- usually 1-4 weeks of age
- Cause malabsoption and hypersecretion
- Co-infection with other agents is common
How would a Cryptosporidium infection be diagnosed?
- Fecal flotation/smear, Sucrose wet mount
- Fixed tissue for histopathology (distal SI)
- PCR
How does Coccidia affect swine neonates?
- affects pigs from 5-6 days to 2-3 weeks of age
- MDx - severe fibrinonecrotic enteritis
- infected Feces
- Rapid sporulation of C.suis in environment (12h) short prepatent period (5 days)
- ingested
- replicates in villous epithelium of SI
- necrosis of epithelium
- Villous atrophy, necrosis, erosion, ulceration, fibrin
- Malabsorptive (& effusive) diarrhea

How is a coccidial infection diagnosed ?>
- Mucosal scrapings/feces (fecal float)
- Fixed SI 9 (histo)
How does E. coli (ETEC) cause neonatal diarrhea?
- Bacteria express adhesion factors that facilitate attachment to enterocyte surface receptors
- Secrete various toxins
- Stimulate cytokines and prostaglandins
- increased secretion/secretory diarrhea
- Profound dehydration
- death
- Attachment and toxin production must be present for disease
- Impossible to differentiate from other causes of neonatal diarrhea at necropsy
- NO villous atrophy
What are the virulence factors of Ecoli for neonatal diarrhea?
- Fimbriae/pilli
- F4 (K88) - receptors are shed as pigs age beyond a few days
- F5 (K99) - receptors are shed as calves age beyond a few days
- F6 (987P) uncommon
- F7 (F41) usually with K99
- F18 (F107) neonates lack receptors, found in weaned pigs
- Fim-A, Paa, AIDA-I
- Toxins
- Heat-labile toxins:
- LT1, LT2 - promote secretion by stimulation of PGs and cytokines
- Heat-stable toxins:
- STa - inhibits Na/Cl transport and water absorption by enterocytes
- STb - secretion and enterocyte exfoliation
- Heat-labile toxins:
Morphologic Dx? Pathogenesis?

- Skin, conjunctiva; subcutaneous and conjunctival edema
- E.coli edema disease
- STEC serotypes O138, 139, 141
- Colonize by F18 fimbriae
- STx2e toxin
- Circulates in blood (enterotoxemia)
- direct vascular injury/angiopathy, edema
- Vaccination with Stx2e toxoid for prevention
- Diarrhea usually not present!
How is E coli edema disease diagnosed?
- Appropriate clinical signs
- appropriate gross and histologic lesions
- Identification of the gent by culture
- genotyping of isolate to identify toxin or pilus genes
- Serotyping (usually agglutination based on O and F antigen types)
What are the Toxins of C. perfringens?
- a - lecithinase causes hemolysis, cell necrosis (Type A)
- B - pore forming toxin (Types B & C)
- inactivated by trypsin
- affects epi- and endothelium
- e - prototoxin activated by trypsin (Type D >B)
- i - prototoxin, increases capillary permeability (Type E)
- CPE (C. perf enterotoxin) - specific toxin pathogenicity unknown, various types
What do the different types of Clostridium sp. do to swine neonates?
- Perfringens
- A - nonatal hemorrhagic diarrhea
- C - necrohemorrhagic enteritis,
- B toxin is trypsin sensiitve
- Difficile - hemorrhagic diarrhea

Morphologic Dx? Pathogenesis?

- SI; hemorrhagic +/- necrotizing eneteritis
- C perfringens is normal inhabitant of GI tract
- microbiome alterations
- overgrowth of c perfrinens
- elaboration of toxins
- necrosis, hemorrhage, etc
What is the diagnostic approach for Clostridial enteric diseases?
- C perf C:
- Gross histologic lesions + culture + genotyping + toxin ID (ELISA)
- C perf A:
- Gross and histologic lesions + culture + genotyping
- must rule out other causes
- Gross and histologic lesions + culture + genotyping
- C diff:
- Clinical signs +gross histologic lesions + culture + Toxin ID (ELISA or PCR)
What is the Dx approach for enteric salmonellosis?
- Clinical signs + gross and histologic lesions + culture (fresh tissue/feces) + Serotyping ID (PCR/sequencing/microarray or serology)
- Serotyping is significant from a public health standpoint


